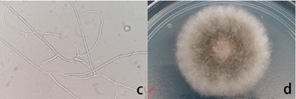
微信图片_20220614153536.png

Enhancement in serum (1–3)-β-D-glucan level by cutaneous alternariosis: A case report and literature review
发布时间2022-06-14 丨 来源:丹娜生物 丨 浏览量 748
前言
链格孢(Alternaria)是暗色丝孢菌中一类常见的真菌,广泛分布于空气、土壤和植物中,亦可在动物皮毛、结膜以及人体中发现,为机会致病性真菌,主要发生于免疫功能低下以及外伤的个体,也可感染正常人群。当前研究主要集中在链格孢感染后患者的临床表现和治疗方法,对辅助检查方面研究甚少。本文报道一例由链格孢引起的皮肤真菌感染患者,患者体内血清G试验检测呈阳性。
病例介绍
入院情况
患者男性,83岁,因“咳嗽咳痰,双上肢均出现局部性皮肤水肿和水疱”入院。患者10年前被诊断为冠心病和骨质疏松症。
诊疗经过
实验室检查结果显示白细胞计数为8.43×109/L,高敏C反应蛋白73.06 mg/L,B型利钠肽59.2 pg/mL,总蛋白50.1 g/L,前白蛋白30.7 g/L,尿素浓度13.35 mmol/L,肌酐152.4 μmol/L,肌酐清除率为31.3 ml/min。患者的血培养、结核菌素试验和γ干扰素释放试验均为阴性。胸部CT显示两肺间质性病变。
患者遵循医嘱通过头孢噻肟、甲泼尼龙、白蛋白等进行对症治疗。10天后,患者肺部感染症状有所改善,但右上肢水疱明显增多。调整抗菌药物为头孢哌酮/舒巴坦钠,但水疱继续增加(图1a)。
吸取水疱液进行微生物培养,涂片显示大量真菌菌丝(图1c),同时在SDA培养基上培养观察到丝状真菌生长,高度怀疑链格孢感染(图1d、1e)。为了进一步确定真菌种属,2天后再次进行了真菌培养得到相同的结果,且G试验(丹娜生物)检测水平>600 pg/mL,呈强阳性结果。通过基因测序对链格孢5个序列(ITS、ATPse、ACT、rpb2和tef1)联合分析进行菌株鉴定,比对结果与链格孢高度一致。遂停用甲泼尼龙,开始伏立康唑治疗。5天后,水疱消退(图1b),患者症状改善出院。
随访情况
患者序贯口服伏立康唑,2周后随访,无复发。

图1.a:患者上肢使用抗生素前水疱以单一或多种形式存在,且易融合在一起;内容物为无色、微浊液体。b:伏立康唑治疗后,水疱消退,取而代之的是褐色疤痕组织。c:提取水疱液,10% KOH,400倍显微镜下观察菌丝呈浅绿色,顶部钝圆,末端细长。d:28 ℃培养3 d后,SDA培养基生长的菌落呈圆形、灰绿色、边缘规则、蓬松。e:400倍显微镜下观察分生孢子呈浅褐色,倒棒状,格子状,纵横分开,顶端有喙状突起,呈长链或树枝状排列。
病例讨论
G试验为泛真菌检测,对念珠菌病、曲霉病和耶氏肺孢子菌感染均有非常好的诊断性能,但很少有G试验对链格孢感染诊断的研究报道。G试验存在一些干扰因素,如使用白蛋白和某些抗生素等可能会引起G试验出现假阳性结果。研究指出当患者在2天内使用>30 g白蛋白时,对G试验检测结果的影响具有统计学意义,如果患者2天内使用>30 g白蛋白时,若提高诊断阈值为203 pg/mL,此时有很好的诊断特异性(84.7%)。本例患者在G试验前接受了静脉注射白蛋白治疗,但剂量为10 g/天,由于剂量不足,对G试验产生的影响微乎其微。另一个可能的影响因素是头孢噻肟的使用,研究表明,在正常输注浓度下,头孢噻肟可导致G试验水平增加到153 pg/mL,但仍远低于本病例G试验的水平(>600 pg/mL),所以该结果可排除为假阳性结果。
该病例表明,G试验可作为链格孢感染的辅助诊断指标,当临床G试验检测呈阳性时,不排除链格孢感染的可能。